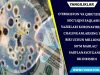
O‘zbekiston va Qirg‘iziston sog‘liqni saqlash vazirlari koronavirusga chalinganlarning har biri uchun millionlab so‘m mablag‘ sarflanayotganini bildirishdi

Putin Yaponiya bosh vazirini rubl bilan muomala qilishga chaqirdi
Rossiya prezidenti Vladimir Putin Yaponiya Bosh vazirini ikki davlat oʻrtasidagi savdo aloqalarida rus rubli bilan muomala yuritishga chaqirdi. Xabarda aytilishicha, Putining bu rejasi AQSh valyutasining global hukmronligini cheklashga qaratilgan.
Putinning bu taklifi Peterburgdagi iqtisodiy forum doirasida “Rossiya-Yaponiya” sarlavhasi ostida boʻlib oʻtgan va ikki davlat oʻrtasidagi iqtisodiy va tijoriy aloqalar koʻrib chiqilgan munozarali majlisda oʻrtaga tashlandi. Majlisda Rossiya prezidenti bilan birga Yaponiya bosh vaziri Sindzo Abe ham ishtirok etdi.
Rublning iyena (Yaponiya pul birligi) va yevro kabi boshqa valyutalarga aylantirish uchun mexanizm yaratish imkoniyatini nazarda tutgan Putin “Rubl valyuta konvertatsiyani qabul qiladigan valyutadir. Shuning uchun rubl bilan muomala qilishni taklif qildik”, deya qayd etdi.
Taʼkidlash joizki, oʻtgan yili Rossiya va Yaponiya oʻrtasidagi savdo hajmi 18,2 milliard dollarni tashkil etgan edi. Uning 10,5 milliard dollari Rossiyaning Yaponiyaga qilgan eksport qiymatini tashkil qilsa, qolgan 7,7 milliard dollari esa Yaponiyadan olib kirilgan import qiymatini tashkil qiladi.
Peterburgdagi iqtisodiy forumning bu yilgi 22 nashri “Ishonch iqtisodiyoti” mavzusida 24-26 may kunlari boʻlib oʻtdi. “arabic.rt.com” saytining xabariga koʻra, bu forum Rossiya iqtisodiyotiga xorijiy investitsiyalarni jalb qilish uchun platforma hisoblanadi.
Turkiston:
Rossiyaning “zaxira jamgʻarma fondi” deyarli tugadi. Bundan tashqari Gʻarb davlatlari, olamiy sistemaning xalqaro siyosat quvvatidan foydalanib siyosiy va iqtisodiy sanktsiyalar qoʻyish orqali uni holdan toydirib boryapti. Putin, shu forumning oʻzida, “Gʻarb olami qizil chiziqni bosib oʻtishi mumkin emas” dedi. Bu qanday chiziq chiziq boʻldi?
Rossiya nima boʻlganida ham, hozircha rasman xalqaro veto huquqiga ega yetakchi davlatlar safida turibdi. Putin, Gʻarb qizil chiziqni bosib oʻtishi bilan, xalqaro huquq nomalarini yoki qonunlarini buzib yuborishini nazarda tutdimi! Negaki uni Yaponiyaga qilgan taklifi, olamiy global moliyaviy sistema printsiplariga teskari yurish boʻldi. Ammo faqat siyosiy bayonot boʻldi xolos. Chunki Rossiya hozirgi olamiy moliyaviy sistemani rublga oʻzgartira olmaydi. Buni hatto YeI yevro valyutasi bilan ham amalga oshira olgani yoʻq. Peterburgdagi forum Rossiya iqtisodiyotiga xorijiy investitsiyalarni jalb qilish uchun platforma emish! Bu tafakkur, mustamlaka mamlakatning siyosiy doirasi emasmi?!
Demak Rossiya iqtisodiy krizisdan chiqish uchun, mamlakatni chet el olamiy investorlariga ochib bermoqchi. Bu siyosiy juda katta xato hisoblansa ham, Putinning bundan oʻzga chorasi yoʻq.